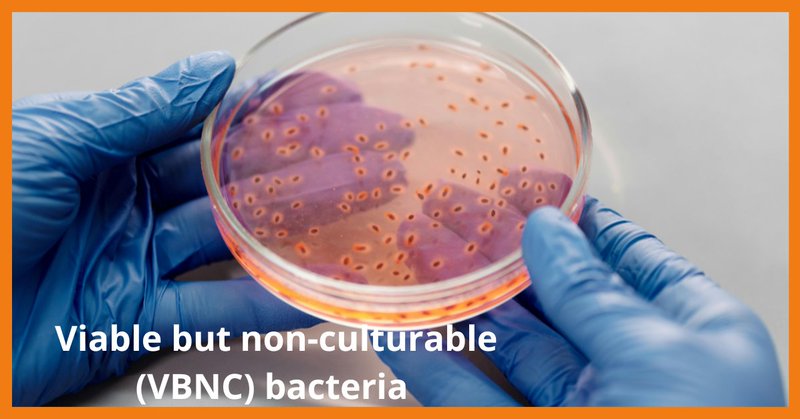
Tweet card summary image

bNovate Technologies SA
@bNovatePR
Followers
39
Following
24
Media
148
Statuses
238
Award-winning mobile lab for online, automated bacterial monitoring in water with reliable results in only 20 minutes. Safe Water. Anytime. Anywhere.
Switzerland
Joined March 2022
Chlorine disinfection remains a cornerstone of safe drinking water supply, but real-time monitoring of its microbiological efficacy is often limited. Watch the full webinar here: https://t.co/yam5rJ4lNH
#webinar #chlorine #chlorinedisinfection #flowcytometrytechnology
0
0
0
Join us for our next webinar on September 4, 2025, featuring our Field Application Scientists Kevin Schuler and Kyle Smetherham. Register now to secure your spot: https://t.co/QbeTMiDwKy We hope to see you there! #flowcytometry #flowcytometrymonitoring #webinar #microbiology
0
0
0
What a day! From the ups and downs (chained or unchained) ⛰️ to indulging in some classic fondue 🫕, to exploring a castle 🏰, and riding a boat ⛴️ to dinner 🍷, our summer event was quite a hit! 🎉 We're proud to be part of the bNovate team. 🦾 #summerevent #hiking #swissalps
0
1
2
Continuous monitoring is essential to consistently meet water quality standards at the point of use. Traditional growth-based methods, such as HPC, are conducted in a lab, tedious, and time-consuming, taking several days. Learn more here:
bnovate.com
Continuous monitoring is essential to meet water quality standards at the point of use consistently. Traditional growth-based methods, such as heterotrophic plate count (HPC), must be conducted in a...
0
0
0
A few weeks ago, our Field Application Scientist was on site with Affinity Water to complete the installation, commissioning, and training of BactoSense CORE. If you're curious to learn more, then check out our website at: https://t.co/8cHvvqZUvA
#microbiology #watermanagement
0
0
0
Join us for our next webinar on September 4, 2025, featuring our Field Application Scientists Kevin Schuler and Kyle Smetherham. Register now to secure your spot: https://t.co/QbeTMiE4A6
#fcm #flowcytometry #flowcytometrymonitoring #webinar #microbiology
0
0
0
A temporary water network was established to ensure the availability of drinking water for this large-scale event. Learn more here: https://t.co/NC7UmgJgZS
#waternetwork #highqualitydrinkingwater #drinkingwater #waterislife
bnovate.com
These strategies can also be deployed in real water distribution networks. BactoSense proved itself to be a valuable tool for bacterial monitoring in drinking water network surveillance, thanks to...
0
0
0
Modern measurement technology, chlorine pumps and shut-off valves are incorporated in an innovative system that guarantees a high-quality water supply. It is based on rain event detection and flow cytometry. Learn more here: https://t.co/4mX7Sp5Qzj
#waterquality
bnovate.com
Modern measurement technology, chlorine pumps and shut-off valves are incorporated in an innovative system that guarantees a high-quality water supply. It is based on rain event detection and flow...
0
0
0
As groundwater provides drinking water to at least 50% of the world‘s population, ensuring a safe and continuous supply of this vital resource is of paramount importance.Learn more here: https://t.co/r3iTE9IFNS
#waterdistribution #waterutilities #waterproduction #watermanagement
bnovate.com
As groundwater provides drinking water to at least 50% of the world‘s population, ensuring a safe and continuous supply of this vital resource is of paramount importance.
0
0
0
Join us for our next webinar on September 4, 2025, featuring our Field Application Scientists Kevin Schuler and Kyle Smetherham. Register now to secure your spot: https://t.co/QbeTMiDwKy We hope to see you there! #fcm #flowcytometry #flowcytometrymonitoring #webinar #microbiology
0
0
0
The maintenance of complex and ageing drinking water distribution networks is a significant challenge for water utilities. However, when pipes burst, immediate action is required. Learn more here: https://t.co/FaJcc1BGTU
#pipeinstallation #maintenance #pipework #watermanagement
bnovate.com
The maintenance of complex and ageing drinking water distribution networks is a significant challenge for water utilities. Careful planning and the use of the right tools help secure a continuous...
0
0
0
We've signed a key new distribution agreement with Food Instruments SRL to enhance water quality and promote environmental compliance in Romania. https://t.co/WWNTFpslPZ
#romania #europe #environmentalcompliance #foodandbeverage
0
0
0
Join us for our next webinar on September 4, 2025, featuring our Field Application Scientists Kevin Schuler and Kyle Smetherham. Register now to secure your spot: https://t.co/QbeTMiDwKy We hope to see you there! #flowcytometry #flowcytometrymonitoring #webinar #microbiology
0
0
0
Our Field Application Scientist, Kyle Smetherham, recently returned from an exciting trip to Asia that combined hands-on installation support with high-profile industry engagement. Big thanks to Matten Plant for their collaboration and warm hospitality! #vietnam #environment
0
0
0
Join us for our next webinar on September 4, 2025, featuring our Field Application Scientists Kevin Schuler and Kyle Smetherham. Register now to secure your spot: https://t.co/QbeTMiDwKy We hope to see you there! #fcm #flowcytometry #flowcytometrymonitoring #webinar #microbiolo
0
0
0
On August 1st, Switzerland commemorates its unity, heritage, and breathtaking landscapes, many of which are shaped by its pristine lakes, rivers, and Alpine waters. 🇨🇭 Wishing everyone a wonderful Swiss National Day filled with joy, BBQs, and maybe a dip in a Swiss lake! 🏔️
0
0
1
Our Channel Sales Manager, Maria Reid, presented BactoSense at the AEDyR Desalination and Reuse Conference 2025 last month. 🌊 BactoSense promotes proactive water quality management through real-time microbial monitoring. Learn more here: https://t.co/8cHvvqZUvA
#waterislife
0
1
0
In pharmaceutical manufacturing, ensuring the microbiological quality of water is critical for product safety and compliance. Let’s explore the primary validation process, its results, and why this innovation is a game-changer:
bnovate.com
In pharmaceutical manufacturing, ensuring the microbiological quality of water is critical for product safety and compliance.
0
0
0
Groundwater catchment for drinking water often takes place in unconsolidated sand and gravel aquifers near rivers. Read more: https://t.co/9P1ulrl1XS
#groundwater #groundwatercatchment #totalcellcount #microbiology
bnovate.com
If water flows through such a layer, it typically attains a high quality and can often be used directly as drinking water. It is of prime importance to monitor the raw water quality to produce...
0
0
0
The inability to detect VBNC pathogens under standard laboratory conditions compromises microbiological safety. In response to this challenge, emerging technologies like BactoSense provide innovative solutions. Learn more here:
bnovate.com
Many bacterial species have been discovered to exist in a viable but non-culturable (VBNC) state, in which cells are alive but unable to grow on standard agar media. As a result, conventional plate...
0
0
0